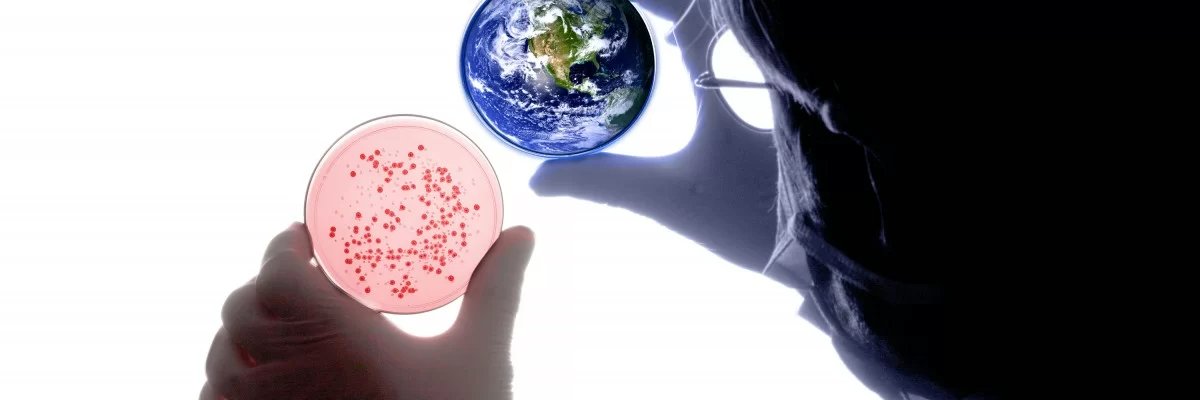
Enfeksiyon Hastalıkları ve Klinik Mikrobiyoloji

Enfeksiyon Hastalıkları ve Klinik Mikrobiyoloji bölümünde; bakteri, virüs, parazit veya mantar gibi mikroorganizmaların neden olduğu ateşli hastalıkların tanı ve tedavisi yapılmaktadır. Bu bölüme bağlı olan klinik mikrobiyoloji laboratuvarında hastalıklara sebep olan her türlü etkenin tespiti için testler gerçekleştirilmektedir. Hastanemizde yatarak tedavi olan hastaların enfeksiyon yönünden takip ve tedavisi, Enfeksiyon Hastalıkları ve Klinik Mikrobiyoloji bölümü tarafından izlenmektedir.
Enfeksiyon Hastalıkları ve Klinik Mikrobiyoloji Bölümünde Tedavisi Yapılan Hastalıklar
- Ateşli Hastalıklar
- Diyabetik Ayak Enfeksiyonları
- Hastane Enfeksiyonları
- Bası yarası (Dekübit Ülseri) Enfeksiyonları
- Grip (İnfluenza)
- Sinüzit
- Boğaz Enfeksiyonları (Farenjit, Tonsilit)
- Selülit ve Diğer Cilt Enfeksiyonları
- Akciğer Enfeksiyonları (Zatürre-Pnömoni)
- Sarılık-Hepatitler (Hepatit A, Hepatit B, Hepatit C vb.)
- Sistit (İdrar Yolu Enfeksiyonu)
- İshaller
- Eklem Enfeksiyonları
- Cinsel Yolla Bulaşan Hastalıklar (HIV, Gonore, Sifilis)
- Kemik Enfeksiyonları (Osteomyelit ve Spondilodiskitler)
- Zoonotik hastalıklar (Bruselloz, Kırım-Kongo Kanamalı Ateşi, Sıtma vb.)
- Yoğun Bakım Antibiyotik ve Enfeksiyon Takibi
- Antibiyotik Kullanımı Takibi